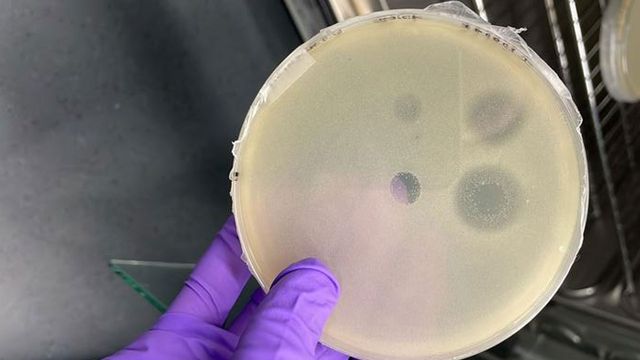

Trending News
News

News
Researchers Track How Iron Deficiency Disrupts Algae Photosynthesis
The researchers found that iron limitation causes up to 25% of light-harvesting proteins in algae to become “uncoupled” from the energy-producing centers, effectively reducing energy conversion.

News
Custom Nanoparticle Unlocks the Anti-Inflammatory Potential of Citrus
Scientists have developed a bio-engineered molecule that uses a natural compound found in citrus fruits to target and treat inflammation.

News
Unexpected Factors Drive Candida albicans Colonization in the Gut
Understanding how Candida albicans colonizes the gut is key to preventing it from becoming harmful, but there are surprising factors at play.
News
New Antibacterials Found in Archaea
How archaea compete with and defend themselves against bacteria has revealed new antibacterials that kill bacteria by targeting the peptidoglycan cell wall.

News
Sex Reversal Is More Common in Australian Birds Than Previously Thought
In a study of nearly 500 birds from five species – including magpies, kookaburras, pigeons and lorikeets – researchers found that up to 6 percent had the physical features of one sex but the genetic makeup of the other.

News
Scientists Discover Dementia-Like Behavior in Pre-Cancerous Cells
In dementia, problematic proteins build up in brain cells, making it harder for the cells to work effectively. Researchers have found that the same process is also linked to pancreatic cancer.

News
People With Obesity Respond to Fasting Differently
Fasting may improve health by changing metabolism to support the immune system, but new research indicates that people with obesity may respond differently.

News
Newly Identified Spinal Cord Neurons Could Boost Breathing After Injury
Case Western Reserve University scientists have discovered a subset of spinal cord interneurons that boost breathing under stress, such as high CO₂ levels. Blocking these cells impaired respiratory function in mouse models.

News
Targeting Striosomes Could Improve Decision-Making in PTSD and Addiction
Scientists from Mount Sinai and UTEP created a computational model showing how striosomes, a compartment in the brain’s striatum, influence decision-making. High activity can cause impulsivity, while low activity may cause indecision.

News
Symbiotic Bacteria Shift Roles to Match Beetle Development and Diet
Researchers found that reed beetle symbionts alter gene activity to meet larval and adult dietary needs, producing amino acids for larvae and plant cell wall–digesting enzymes for adults.
Advertisement






